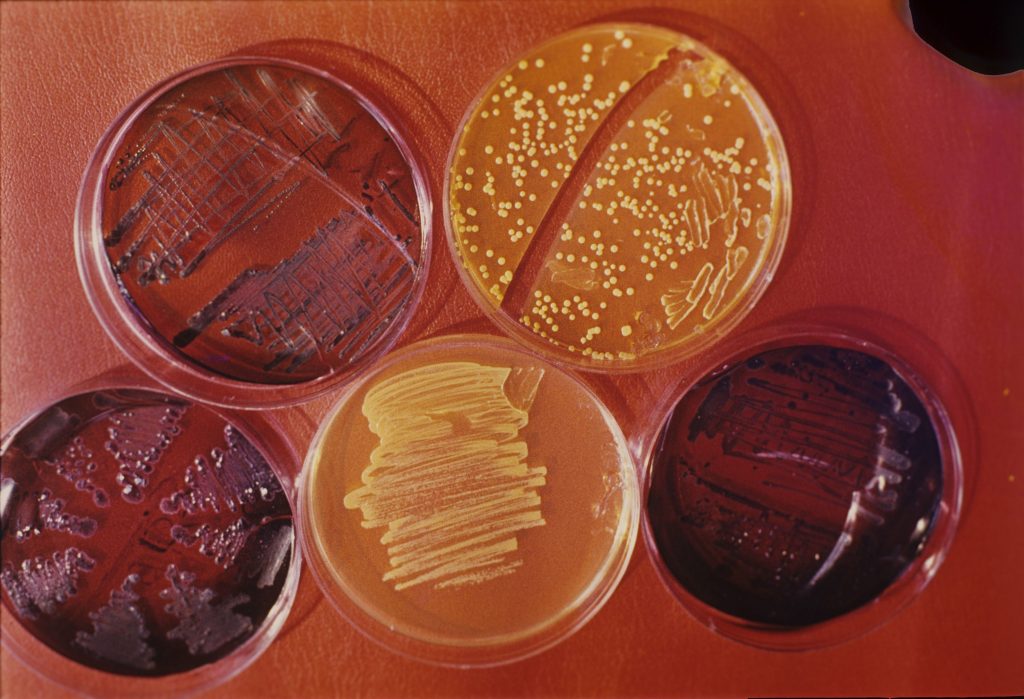
Bacteria „Legionella” a fost identificată ca fiind cauza unor misterioase epidemii de pneumonie în Argentina

Argentina relaxează legislația anti-evaziune
De-a lungul anilor de inflație ridicată și control valutar, argentinienii și-au schimbat sumele deținute în moneda națională pesos, în dolari, pe care adesea îi păstrau […]


De-a lungul anilor de inflație ridicată și control valutar, argentinienii și-au schimbat sumele deținute în moneda națională pesos, în dolari, pe care adesea îi păstrau […]

Incidentul a avut loc în timpul meciului din liga argentiniană. Clubul spune că „nu a existat nicio situație violentă în tribună”. Oficialii River Plate au […]

Capitala Argentinei a fost martora unor sărbători uriașe. Naționala argentiniană a învins Franța în ultimul meci din Qatar. Potrivit El Financiero, oficialii Băncii Centrale studiază […]

Finala Cupei Mondiale de fotbal, programată duminică (ora 17.00), între Franţa, actuala deţinătoare a titlului suprem, şi Argentina, suscită interes nebun în întreaga lume. De […]
Victimele au raportat febră mare, dureri de corp și dificultăți de respirație. Alte cazuri au fost identificate, de asemenea, în aceeași clinică în care erau […]

Luna trecută a fost nevoie de doar 24 de ore pentru ca guvernul premierului Narendra Modi din India – al doilea mare producător mondial de […]

Cel puţin 20 de persoane şi-au pierdut viaţa şi 74 au fost internate, în suburbiile oraşului Buenos Aires, după o intoxicare masivă cu cocaină contrafăcută, […]

Peste jumătate de kilogram de cocaină şi amfetamină, ascunse în filtrul de aer al motorului, au fost descoperite de procurorii și polițiștii ieșeni, chiar în […]

Spania a învins, miercuri, cu scorul de 29-13, în primul meci din cadrul Campionatului Mondial de handbal feminin pe care îl găzduieşte şi la care […]

Argentina și Brazilia au dat-o la pace în preliminariile Campionatului Mondial de fotbal,0-0.